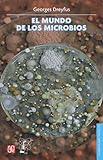
Imagen de portada de Amazon

El mundo de los microbios / Georges Dreyfus Cortés
Por: Dreyfus Cortés, Georges [autor/a].
Tipo de material: Libro
impreso(a)
Series Editor: Distrito Federal, México: Fondo de Cultura Económica Secretaría de Educación Pública Consejo Nacional de Ciencia y Tecnología, 2007Edición: Cuarta edición.Descripción: 95 páginas : ilustraciones ; 21 centímetros.ISBN: 9789681682590.Tema(s): Microbiología
Libro
impreso(a)
Series Editor: Distrito Federal, México: Fondo de Cultura Económica Secretaría de Educación Pública Consejo Nacional de Ciencia y Tecnología, 2007Edición: Cuarta edición.Descripción: 95 páginas : ilustraciones ; 21 centímetros.ISBN: 9789681682590.Tema(s): Microbiología| Tipo de ítem | Biblioteca actual | Colección | Signatura | Estado | Fecha de vencimiento | Código de barras |
|---|---|---|---|---|---|---|
| Libros |
Biblioteca Campeche
Texto en la configuración de la biblioteca Campeche |
Acervo General | F 576 D7 | Disponible | ECO040006594 |
Agradecimientos.. Introducción.. I. Los principios de la microbiología.. I.1. Las primeras ideas.. I.2. Las primeras observaciones.. I.3. La controversia de la generación espontánea.. I.4. Cómo son las bacterias.. II. Metabolismo bacteriano.. II.1. Las enzimas son eficiencia y rapidez.. II.2. Unos seres vivos dependen de otros.. II.3. La actividad metabólica aumenta o disminuye.. II.4. Fases del metabolismo.. II.5. La maquinaria del metabolismo.. II.6. Bacterias fotosintéticas.. III. Las bacterias y la historia de la Tierra.. III.1. Las arqueobacterias, una antigua forma de vida.. III.2. Bacterias fósiles.. III.3. La bioquímica y la evolución.. III.4. Un modo de vida diferente.. IV. Los microbios al servicio del hombre.. IV.1. La vida con o sin oxígeno.. IV.2. La manipulación genética.. IV.3. La industria y sus pequeños aliados.. Lecturas recomendadas
"Una pregunta que el ser humano se hace con frecuencia -nos dice el autor en la introducción a su obra- es si hay vida en otros planetas. Sin duda un descubrimiento así sería revolucionario. Imaginemos lo que sintieron quienes vieron por primera vez, bajo sus microscopios, seres diminutos que habían pasado inadvertidos; se abrió un mundo nuevo: el de los microbios. En diversos sentidos este hallazgo fue tan importante como si hoy se descubriese que hay vida en otro planeta. Así pues, este libro empieza con la descripción de cómo la humanidad se dio cuenta de la existencia de los microorganismos -lo que le permitió explicar la causa de algunas enfermedades- hasta el grado de crear una ciencia encargada de su estudio. Estos pequeños organismos han propiciado el desarrollo del conocimiento sobre los aspectos bioquímicos de la vida." En estas páginas el lector seguirá la historia de cómo los microorganismos se han adaptado a diversos ambientes -algunos tan extremos que semejan quizá las condiciones que prevalecían en nuestro planeta hace miles de millones de años- y de cómo han constituido una ayuda invaluable en el estudio del origen de la vida. spa